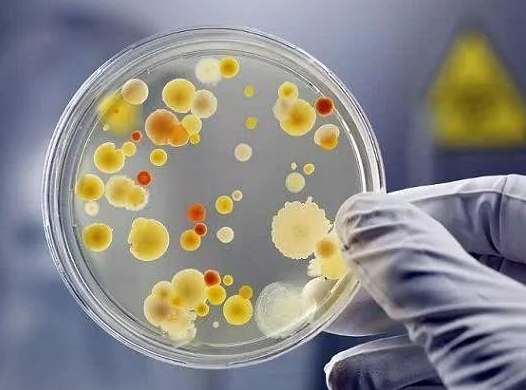

外边路边摊小吃,受着汽车尾气和粉尘的侵袭,你会对此嗤之以鼻,殊不知,在传统家庭每日开火爆炒油炸中,一不注意,厨房所积聚的细菌总量可能比起路边摊还要多。
在国外科学基金的一项研究当中,家庭中细菌数量最密集的地方不是卫生间,而是厨房。

长期用来擦拭台面的洗碗布,细菌数最多,每平方厘米便大概有6000个细菌,比起卫生间清洁口腔的牙刷还要高150倍;厨房水槽细菌含量是马桶座的200倍;而放在台面上、橱柜内的家电按钮、把手,也是细菌重灾区。

有没有发现,虽然这些细菌分布在厨房的多个地方,但都是分布在厨房的操作台台面或者附近的地方。也即是说,当你把手机、便当盒、皮包、信件、筷子和汤匙放在操作台上,这些细菌就会蔓延到这些物品上!
空间抗菌台面,能大范围抗击细菌
我常在想,有没有一个“神器”既能抵抗操作台上的细菌,又能对付操作台附近的把手、五金器皿甚至放在台面上便当盒的细菌。
市面上产生越来越多的这种需求,做抗菌台面十余年的戈兰迪便加紧了研发,在今年初,推出了第三代抗菌技术。
戈兰迪的第三代抗菌技术不但能够实现抗菌率达到99.9%,而且还能做到一定空间范围内抗菌。即围绕在戈兰迪抗菌台面上及周边的细菌都会被抑制。
而且空间抗菌意味着不需要接触便可以达到抗菌的效果,你的手机和物件并不需要真正放到台面上,只需在台面周边停留,部分的菌落数也因此被抑制和抵抗杀除。
这是两杯分别放在不同台面的伊利牛奶,在常温下,分别放在普通台面和戈兰迪抗菌台面约3天的时间。

在普通台面上放置3天

在戈兰迪抗菌台面上放置3天
放在普通台面的牛奶因自然发酵而霉变,而另一杯牛奶因为置于戈兰迪抗菌台面上,依旧保持较好的状态。这些测试即便是消费者,也可以亲自做测试。
在显微镜下可以观察,加入抗菌技术后的台面,8小时后,可以明显看出细菌数量的变化:

显微镜下的细菌

加入戈兰迪抗菌技术8小时后
如果还有疑虑,戈兰迪抗菌台面敢于做出如此的保证,一旦在权威机构检测抗菌无效,即可实现赔付!这实打实的操作,也能打消了消费者最后的疑虑。
有老人孩子的家庭,尤其需要抗菌台面
戈兰迪抗菌台面,不仅达到食物级别卫生标准,不含对人体有害的物质,而且无毒无辐射,可直接接触人体皮肤,无须担心日常烹饪中洗切时,生鲜食物、熟食交替接触台面而产生的交叉感染。
有人说细菌不一定是有害的,但是经实验,厨房的台面和用具往往滋生出大肠菌群、霉菌、沙氏门菌、粪球菌等有害细菌。沙门菌抵抗外界力较强,在水、肉类食品中可存活一年,还有一些发霉的饭菜,含有国家一级致癌物黄曲霉素,这堪比砒霜还要毒68倍。
如果使用了抗菌台面,我们就不需要过分担心食物会滋生更多细菌,也无须过分担心小孩从台面上去拿食物,或者担心食物这么快就霉变。
技术小小的进步,却能够换来家庭生活中大大的进步!
日本SIAA、十余年抗菌经验作为背书
戈兰迪携带第三代抗菌台面在2021年厦门石材展亮相,便引起了极大的反响。
戈兰迪是全球首家加入日本SIAA抗菌协会的人造石企业(日本SIAA认证标志是由抗菌制品技术协会自1998年起开始使用,代表符合标准规定、可被信赖的产品,在抗菌性、安全性及标注方面都要求很高),并且拥有十余年抗菌技术和实践经验。

戈兰迪第三代抗菌技术不但做到抗菌率99.9%,而且在24小时的甲醛去除率达到85%,不含重金属,全程无辐射,安全环保有效。该抗菌技术已经通过日本石塚硝子抗菌检测和日本BOKEN抗菌检测,是市面上可推行的有资质证明的可靠产品。
细菌看不见摸不着,但并不代表不存在,2020年爆发的新冠疫情无疑给广大家庭敲响了警钟。
我们不需要表面上的伪健康,我们需要健康赋能的功能性和实用性兼具的台面。
如今国外疫情还没得到全面控制,毋庸置疑,抗菌将成为今后消费的刚需,与其观望别的品牌在健康抗菌道路上迎头赶上,不如尽快使用戈兰迪第三代抗菌技术,让专业定制化精准的技术应用方案运用到您的台面上去。
一屋两人三餐四季,让人间烟火更为安全、更为放心。我们应该为家做出更优质的选择!
